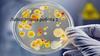
Мікробіологія. Лабораторна робота 1

Похожие презентации:
Мікроскопічні методи дослідження
1.
Мікроскопічніметоди
дослідження
2.
Види мікроскопіїСвітлова
мікроскопія
Рентгенівська
мікроскопія
Електронна
мікроскопія
Скануюча
силова
мікроскопія
Методи
мікроскопії
видимого світла
Трансмісійна
ЕМ
Тунельна
Ультрафіолетова
мікроскопія
Скануюча ЕМ
Атомно-силова
мікроскопія
Інфрачервона
мікроскопія
Близькопольна
оптична
мікроскопія
3.
Світловамікроскопія
Методи мікроскопії
видимого світла
Ультрафіолетова
мікроскопія
Інфрачервона
мікроскопія
Мікроскопія у
відбитому світлі
Класична УФмікроскопія
Класична ІЧмікроскопія
Метод світлого поля
Люмінісцентна
(флюоресцентна
мікроскопія)
Двофотонна
мікроскопія
Спеціальні методи
світлової
мікроскопії
Конфокальна
мікроскопія
Методи мікроскопії
надвисокої
роздільної здатності
4. Будова світлового мікроскопа
ОПТИЧНА СИСТЕМАокуляр
лінзи бінокулярної
насадки та тубусів
об’єктив
МЕХАНІЧНА
СИСТЕМА
бінокулярна
насадка, тубуси
револьверна голівка
штатив
предметний
столик з
препаратоводієм
макрогвинт
конденсор,
ірисова
діафрагма,
фільтри
джерело світла
гвинт
конденсора
мікрогвинт
основа
5.
основа та дзеркальцетубус без окуляра
6.
7.
предметнийстолик з
препаратоводієм
предметний
столик
8.
револьверна голівказ об’єктивами
макро та мікрогвинти
9.
10.
11.
макрогвинтмакрогвинт
та
мікрогвинт
12.
конденсор ідіафрагма
предметний столік
(знизу), конденсор,
ніжки станіни
13.
дзеркальце, конденсор14.
Інвертований мікроскоп15.
Схема бінокулярної насадки16.
Бінокулярнілабораторні
мікроскопи
17.
Мікроскопипорівняння
18.
Порівняльний мікроскоп убалістичній експертизі
19.
Стереомікроскоп20.
Тринокулярний мікроскоп21.
22.
Прижиттєве дослідження структур. Цейтраферна зйомкаДроблення зиготи морського їжака
(фазово-контрасна мікроскопія)























 Биология
Биология